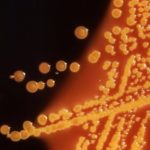
Primul organism sintetic

Unul din cele mai mare mistere ale biologiei a fost rezolvat cu ajutorul Inteligenței Artificiale (IA), au anunțat experții.Prezicerea modului în care o proteină se împreunează într-o formă tridimensională unică i-a nedumerit pe oamenii de știință timp de o jumătate de secol.Laboratorul de IA din Londra, DeepMind, a rezolvat în mare măsură problema, au declarat … [Read more...]
Continue oare oamenii să evolueze? Oamenii de știință răspund
Ca specie, oamenii au populat aproape orice colţ al Pământului.Noi am dezvoltat tehnologii şi culturi ce modelează lumea în care trăim.Ideea "selecției naturale" sau a "supraviețuirii celui mai adaptat" pare să aibă sens în epoca epocii de piatră, când noi ne luptam pentru resturi de carne, dar mai este aceasta valabil în zilele noastre?!2 experți au fost întrebați … [Read more...]
Polinezienii şi americanii nativi au contactat înainte de sosirea europenilor, potrivit unui studiu genetic
În urma unei analize genetice profunde, oamenii de știință de la Stanford Medicine şi colaboratorii lor au găsit dovezi concludente ale contactului dintre polinezienii străvechi şi americanii nativi din regiunea care acum se numește Columbia — ceva ce era contestat aprig zeci de ani în cercurile istorice şi arheologice."Genomica este la o etapă la care poate aduce … [Read more...]
Un ADN „fantomă” a fost găsit în vest africani şi asta complică istoria originii umane
În urmă cu aproximativ 50 000 de ani, oamenii străvechi din regiunea care acum este Africa de Vest s-au reprodus cu un alt grup de oameni străvechi, despre care oamenii de știință nu știau că există.Nu există oase sau ADN-uri vechi ce ar dovedi acest lucru, dar cercetătorii spun că dovezile se conţin în genele vest-africanilor moderni.Ei au analizat materialul genetic … [Read more...]
Oamenii de știință au descoperit un misterios virus cu gene necunoscute pe care nu le-au putut identifica
Oamenii de știință au identificat un virus enigmatic al cărui genom pare a fi complet nou pentru ştiinţă, cu gene necunoscute ce niciodată nu au fost documentate în cercetările virale.Aşa-numitul Yaravirus, numit în cinstea Yara — sau Iara, o regină a mării din mitologia braziliană — a fost recuperat din lacul Pampulha, un lac artificial din oraşul brazilian Belo Horizonte. … [Read more...]
O nouă metodă radicală poate edita direct celulele umane pentru a remedia bolile genetice
Oamenii de știință din SUA au dezvoltat un nou sistem puternic de editare a genomului, care ar putea oferi o precizie şi o eficienţă semnificativ mai mare decât actualul standard CRISP.Deşi, CRISP-Cas9 este o tehnologie medicală revoluționară ce a pus bazele moderne pentru editarea codului genetic — inclusiv a variațiilor legate de boală — de mult timp au existat … [Read more...]
Un ADN vechi revarsă mai multă lumină asupra filistenilor biblici
O echipă de oameni de ştiinţă au secvenţiat genomi a oamenilor ce au trăit într-un oraş portuar de pe coasta mediteraneană a Israelului între secolele XII şi VII î.e.n.Undeva în secolul al XII-lea, o familie din oraşul vechi Ashkelon, din Israel, şi-a plâns pierderea unui copil.Dar ei nu au mers la cimitirul orașului.În schimb, ei au săpat o groapă în podeaua … [Read more...]
A fost creat primul organism viu din lume cu ADN-ul complet reproiectat
Cercetătorii au creat un genom sintetic modificat, cu potențiale beneficii pentru medicină pe viitorOamenii de știință au creat primul organism viu din lume care are un ADN complet sintetic şi radical modificat.Microbul creat în laborator, o tulpină de bacterii răspândită în mod normal în sol şi în intestinul uman, este similar cu verișorii săi naturali, dar … [Read more...]
Ea niciodată nu a simțit durere sau anxietate şi acum oamenii de știință știu de ce
Descoperirea făcută la o femeie în vârstă de 71 de ani, Joe Cameron, ar putea ajuta la dezvoltarea unor noi tratamente de ameliorare a dureriiDoctorii au identificat o mutație la o femeie care abia poate simți durerea sau stresul, după ce un chirurg derutat în privința recuperării ei din urma unei operații, a îndreptat-o la o testare genetică.La vârsta de 71 de ani, Jo … [Read more...]
Făceţi cunoştinţă cu fructul ciudat care în curând poate deveni la fel de răspândit ca căpşuna
Denumirea sa nu este apetisantă: el este numit groundcherry (cireaşă de pământ).Posibil puțini din voi ați auzit despre acest fruct, dar cu unele modificări genetice, el ar putea deveni un product de bază în supermarketuri mai devreme decât aţi fi crezut.Asta pentru că oamenii de ştiinţă au folosit fructul groundcherry ca un caz experimental de testare, pentru a ilustra … [Read more...]